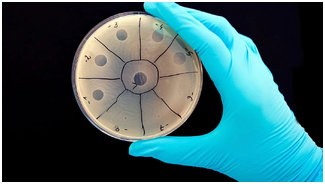
Бактериальных инфекций / Бактерии
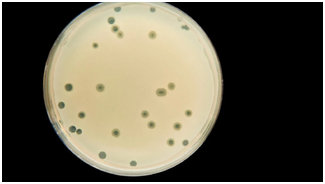
Бактериальных инфекций / Бактерии

Учёные создают вирус для уничтожения бактерий
Мир на данный момент находится в состоянии войны с микроорганизмами, которые невозможно увидеть невооружённым глазом, и если их не остановить, они могут убить миллионы людей в ближайшие годы. И речь не о новейшем коронавирусе, к которому на данный момент приковано всё внимание, а о бактериях, устойчивых к антибиотикам.
Дело в том, что только в прошлом году от бактериальных инфекций в мире умерло более 700 000 человек. Если ничего не делать, это число может возрасти до 10 миллионов в год к 2050 году, в соответствии отчёту ООН. Проблема заключается в злоупотреблении антибиотиками. Люди применяют крайне много лекарств, чтобы убивать вредные микроорганизмы, которые научились приспосабливаться.
Биотехнологическая компания Felix полагает, что может предложить новый подход к предотвращению распространения бактериальных инфекций при помощи вирусов.
На данный момент, в ходе всеобщего кризиса, который вызван коронавирусом, кажется странным смотреть на вирус в хорошем свете, однако, как поясняет соучредитель Роберт Макбрайд (Robert McBride), ключевая технология Felix позволяет ей направлять свой вирус на определенные участки бактерий. Это мало того, что убивает вредные микроорганизмы, однако также может остановить их способность развиваться и становиться устойчивыми.
Felix планирует начать лечение бактериальных инфекций у людей, страдающих муковисцидозом, по причине того, что этим пациентам, в основном, требуется постоянный поток антибиотиков для борьбы с лёгочными инфекциями. Следующим шагом будет проведение небольшого клинического испытания с участием 30 человек, после чего, в основном, в ходе модели научных исследований и разработок, — более крупное испытание на людях до получения одобрения FDA (Управление по контролю за продуктами и лекарствами США). Пройдёт много времени, однако господин Макбрайд рассчитывает, что их подход с программируемыми вирусами поможет противостоять росту устойчивости бактерий к антибиотикам.

0 комментариев